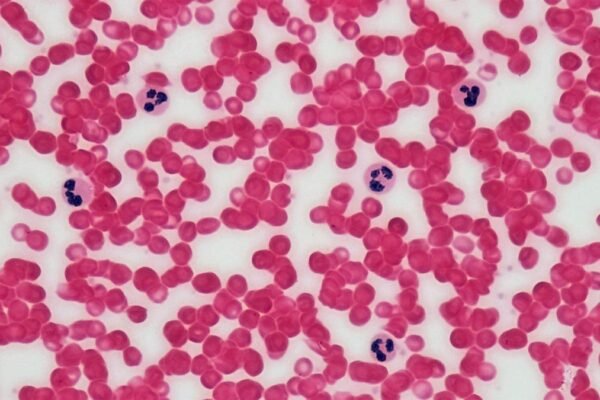

2026 Jeep Meridian launched: New price, upgrades explained
Jeep India has launched the 2026 Jeep Meridian SUV in the Indian market. The higher-spec Limited (O) and Overland trims now feature a manually sliding second-row seat. The adjustable rear bench operates on a 60:40 configuration, allowing the larger portion of the seat to move back and forth by up to 130mm, while the smaller…